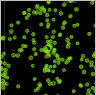

(10,10) Nanotube

(10,5) Nanotube

A bundle

MWNT

Rotation

Vibration of DWNT

DWNT

Vibration of SWNT

SWNT

Peapod Formation
Peapod Formation

Vibration of Peapod

Fuse of C60
Inside SWNT

Peapod

Growth of SWNT
from metal cluster

NiC60 Cluster

Growth of SWNT
in Gas phase

Elongated Structure

Annealing

Water@(10,10)

Water@(20,20)

Nanohorn & H2

Nanotube & H2

C70@(10,10) at 10K

C70@(12,12) at 10K

C70@(10,10) at 300K

C70@(12,12) at 300K

C70@(10,10) at 300K





















